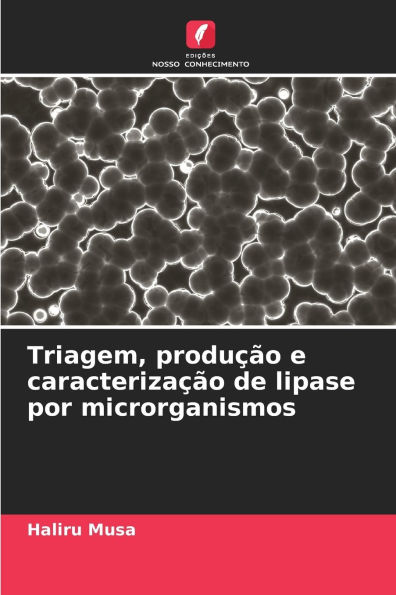
Triagem, produÃ¯Â¿Â½Ã¯Â¿Â½o e caracterizaÃ¯Â¿Â½Ã¯Â¿Â½o de lipase por microrganismos

Home
Caracteriza��o de revestimentos por pulveriza��o a frio
Barnes and Noble
Loading Inventory...
Caracteriza��o de revestimentos por pulveriza��o a frio in Franklin, TN
Current price: $52.00

Barnes and Noble
Caracteriza��o de revestimentos por pulveriza��o a frio in Franklin, TN
Current price: $52.00
Loading Inventory...
Size: OS
O presente programa de investigação tem por objetivo caraterizar comparativamente os revestimentos por pulverização a frio (NiCrAlY, NiCoCrAlY e Inconel625) depositados em superligas disponíveis no mercado (SuperNi76, SuperNi600 e Superfer800H), em laboratório, relativamente às suas propriedades. O revestimento de NiCrAlY, NiCoCrAlY e Inconel625 pulverizado a frio foi caracterizado utilizando diferentes métodos. A caraterização dos revestimentos de NiCrAlY, NiCoCrAlY e Inconel625 pulverizados a frio foi discutida com a literatura aberta.
O presente programa de investigação tem por objetivo caraterizar comparativamente os revestimentos por pulverização a frio (NiCrAlY, NiCoCrAlY e Inconel625) depositados em superligas disponíveis no mercado (SuperNi76, SuperNi600 e Superfer800H), em laboratório, relativamente às suas propriedades. O revestimento de NiCrAlY, NiCoCrAlY e Inconel625 pulverizado a frio foi caracterizado utilizando diferentes métodos. A caraterização dos revestimentos de NiCrAlY, NiCoCrAlY e Inconel625 pulverizados a frio foi discutida com a literatura aberta.